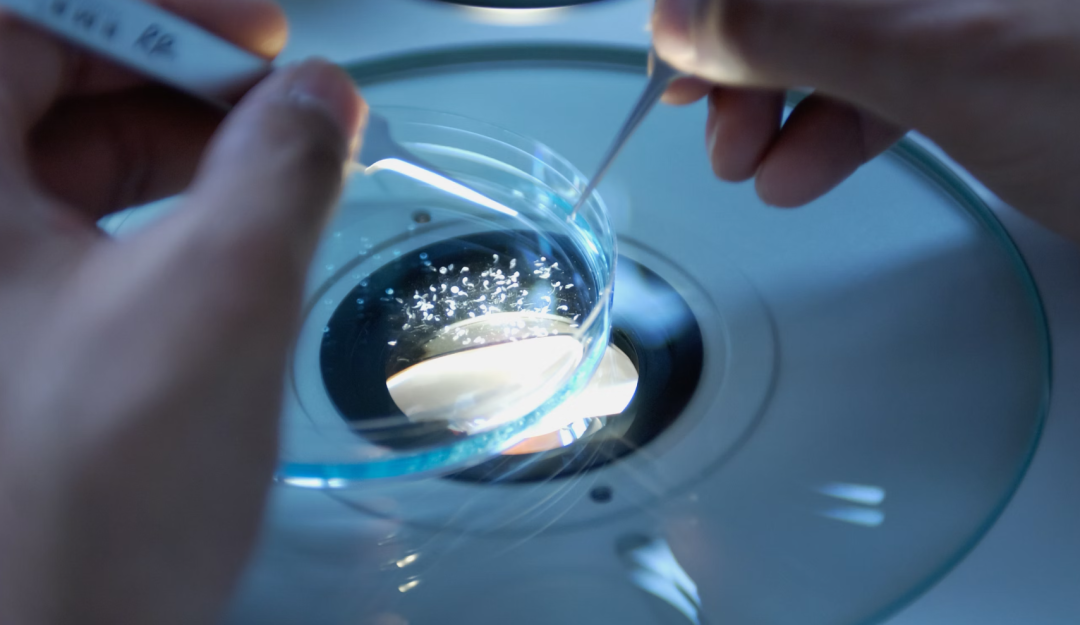

文|定焦 唐亚华
编辑|黎明

即将告别2023,回望这一年,创业投资圈呈现“冰火两重天”的景象。
相对前几年的创投热潮,2023年算是冷清的一年。由于过去几年的投资退出不算理想,很多投资机构或“子弹”不足,或正在重构投资逻辑,犹豫观望,鲜少出手。
而且,最近几年,资本泡沫褪去,创业门槛被提高了很多,加上移动互联网领域的场景逐渐到顶,市场上活跃的创业项目大大减少。
但2023年也有不少领域或初登舞台就大放异彩,或稳定上升并日趋火爆。比如,AI井喷式爆发,大模型竞相追逐;硬科技依然是政策和资本追捧的“潜力股”;出海成了大多数企业追求增量的法宝;理性消费的浪潮下,不少高性价比的消费项目也涌现了出来。
对于马上到来的2024年,投资人保持谨慎的乐观。AI热潮的延续是确定性的,探索更多AI原生场景,将AI的应用从消费领域扩展到生产制造领域,从软件延伸到硬件上,都是有潜力的方向;消费也是永恒的话题,高性价比的品牌、线下体验型消费项目有机会迎来爆发,国货出海也将是一大趋势;而以航空航天、低空经济、生物医药为代表的前沿科技仍旧在发展红利期。
如今的创业门槛虽高,但高精尖人才和普通从业者都有适合各自的机会。创业者要做的是,不焦虑、不盲目,立足自身优势和业务本身,积极拥抱新技术、新潮流,搭上时代的快车。
AI的新战场:原生场景、产业化、软硬件结合
2023年,AI几乎成了贯穿全年的热门创业投资赛道,AI的超能力已经初步被验证,而且其潜力还在不断被开发。基本可以确定,2024年,创投圈AI热会延续。
新的机会在哪里?AI原生场景的探索、从消费端向产业端转移、从软件向硬件扩展,是几大方向。
英诺天使基金合伙人王晟向「定焦」表示,2023年虽然AI很火,但资金端和资产端都比较收敛,真正活跃投资的VC不多,大约有二十来家,项目领域也不算广泛,集中在大语言模型和AI硬件网络基础设施如算力等上面。在他看来,明年资产端和资金端开口都会更大,会有更多的VC投资和更多领域的项目涌现。
至于具体方向,王晟看好的是多模态大模型和AI原生应用。“多模态大模型可能会向动态视频方向去突破;在应用上,创业者可以去游戏、社交、娱乐、情感陪伴、培训等领域找到AI的原生应用和场景。我们希望能够涌现出来很多过去没有的应用,就像移动互联网时代的美团、滴滴、拼多多,而不仅仅是把AI当成一种提高效率的工具。”
AI目前的落地和商业化在一些细分领域已经能看到了。红杉资本前投资人、科技创业加速器QAQ合伙人杜雨举了一个他最近看过的早期项目作为例子。他介绍,这家公司用AI机器人做心理咨询,因为AI能够24小时服务客户,到了晚上通常心理咨询师睡觉了,但很多抑郁的人在这个时段更需要咨询和陪伴,这时候AI的价值就体现出来了,且这个项目从成立之初商业化就做得很不错。

杜雨指出,AI的下一步趋势是从消费端往产业端转,从消费场景拓展到产业和工业场景,AI在生产制造环节也能让工厂的批量生产更加高效,同时AI对于新材料、生命科学、半导体等产业领域将起到推动作用。
长期关注美国硅谷创业投资的美国盛达国际投资公司(Granday International investment LLC )创始人吴巍补充,AI在工业和制造、医疗、金融领域的应用接下来将会进一步发展。
“工业和制造方面,AI和机器学习在工业自动化、预测性维护、质量控制等方面有着广泛的应用。投资者可能会寻找那些能够提升生产效率和降低成本的AI解决方案。”
同时,医疗保健行业对于AI的应用有着广泛的需求,包括疾病诊断、药物研发、医疗图像分析等。他看好为医疗领域提供创新解决方案的公司,这一类的标杆公司有:Tempus(利用人工智能和数据分析来改善癌症诊断和治疗)、IBM Watson Health(在医疗保健数据分析和认知计算方面有解决方案)。
另外,吴巍提到,金融科技领域将继续受益于AI的创新,包括信用评估、风险管理、交易自动化等方向。
AI应用从软件到智能硬件,也是接下来的趋势。
吴巍认为,自动驾驶、机器人等领域应用深度学习技术的创新公司会受到投资人青睐。
现在很多车企开始把大模型用在智能驾驶和机器人领域,还有一些智能家电公司也在尝试将AI的一些功能结合到家电上。
方向是清晰的,但身在其中的创业者难免会感到迷茫。
在和创业者交流的过程中,杜雨发现,不少创业者对新技术或过于焦虑或抱有太大希望,他认为,创业者首先心态要稳,先回归到业务本身,少一些技术焦虑,同时要认识到技术的局限性,AI是辅助业务的,不要指望本来业务一般有了AI之后就能翻盘,从而舍本逐末。AI能起到降本增效的作用,但它很难解决业务本身的短板,从底层去改革业务。
另外,他建议与实体产业关联密切的企业拥抱AI的时候,需要先提高业务的数字化程度,数字化是智能化的前提。最后,他认为要给更多年轻人机会,“在AI的这一波创业中,有年轻化的趋势,传统产业很多时候其实卡在了老一辈企业家的认知障碍上,拥抱新技术,相关的决策可以更多地放权给年轻人。”
不过,AI的创业机会也分为走资本化道路的创业和适合普通人的生意。
VC愿意投资的项目,通常需要强壁垒、高成长性。“AI领域如果要走资本市场做上市公司,更适合科技型人才”,杜雨说,对于普通人来说,可以做的创业不一定是资本市场能给很高估值的模式,但是它可以是一门生意,比如,给AI做语料标注,这种劳动密集型模式,没有太高的技术壁垒,投资人可能不会看,但这方面的创业者至少在最近一两年里能挣到钱。
消费关键词:消费+AI、性价比、国货出海
消费永远有市场,只是不同的时期用户消费心理不同,消费行业永远待探索。
资深消费领域投资人陈默默接下来比较关注的是AI在消费场景的应用。
她解释,AI在消费领域主要是两端,一个研发端,一个投放端,这两端本身就是数据驱动,只是原本由人来数据化,现在用AI能更好地提效。目前已经有一些公司的研发环节用AI加快筛选和研究效率。投放端包括内容剪辑、投放效率动态监测和复投,在服务端和内容端,都可以用AI驱动,赋能消费品牌。最终,AI会让更符合消费者需求的产品更快产生。
在陈默默看来,这个机会有可能是某个消费品品牌的,也有可能是第三方服务公司的。挑战在于,需要这样的公司同时对技术、产品和用户有比较深的理解。
到了消费体验型领域,陈默默提到,今年演唱会等很火爆,明年她依然看好线下体验型消费项目,尤其是重体验、重互动,和消费者产生深度链接并提供精确满足用户需求产品的方向,比如各类更细分多元的服务项目,或者互动体验内容及相关的产品等。
具体到消费的细分行业,坚果创投创始人、诸葛开店创始人展豪看好的是高性价比的连锁餐饮。
在他看来,近年来的流行趋势不应该叫消费降级,而是消费清醒,消费者越来越关注很多东西本身,越来越理性。他投资的项目中显露出了几大趋势:店面小型化、装修简约化、爆款集合。

他解释,以前消费者觉得去一家大店吃饭很有面子,消费清醒之后大家认为,店面只要能满足需求就行,这时候,店面小型化就变得合理且经济;装修上,现在流行的工业风、侘寂风、性冷淡风,非常简约,商家把钱都用在食材上,消费者会觉得买到的东西足够有性价比。
此外,展豪注意到,现在单品爆款店不如爆款集合店的效果好。据他介绍,现在每一批客人平均是2.6个人,三个人一起进店吃饭,可能想吃拉面、盖饭、饺子的都有,爆款集合店能同时满足几个人的需求,门店的复购率也会更高。
他把这种店概括为“麻沙拉黄”,即麻辣烫、沙县小吃、拉面、黄焖鸡米饭的集合,几种经典快餐或日常小吃放在一起,再加点卤味、小吃、烤串就是休闲分享餐,类似的店比如南城香。
展豪投资的项目村上一屋之前主做日本料理,近期考虑到顾客可能担心食品安全问题,调整成了亚洲融合菜小馆,里面有冬阴功汤、朝鲜部队锅,菜品丰富度提升,人均客单价降低,一个月后销售额就恢复了。
展豪目前基本上都是按上述逻辑在投资餐饮项目。
不过,他建议餐饮行业的初级创业者这个阶段不要再去做餐饮品牌,因为餐饮的门槛已经被越拉越高。
“这一行淘汰率极高,最终能跑出来的餐饮创始人大多都非常厉害。餐饮小白可以考虑加入已经被市场验证过的连锁餐饮企业。”展豪说。
他预测,2024年餐饮领域会有很多品牌出现,也会有很多赚不了钱的企业退出,现实会逼着大家进步。“当大家有一天吃到的东西无论是性价比还是口味都超过自己在家做饭时,连锁餐饮就到了正确的轨道上了。”
出海,或者说全球化,也是接下来延续的一大趋势。
陈默默认为,之前大众对国货或国产产品固有的概念是主要依靠成本优势,主打低价,其实现在国内的很多东西实际上放在国际上也在前列,比如生物科技、创新型原材料、消费品、医疗机器人等领域的很多新产品不仅服务国内的市场,也很有机会到国际上去竞争。“前两年的出海是拿价格优势去卷,但本身能打的产品,可以国内国外一盘货,同时发布,只是需要在不同国家去做合规和采用不同的打法而已。”
辰锋资本董事总经理黄自成举例,目前把市场放在国际的企业表现整体不错,像比亚迪等。他补充,创业者还有一个思路是,因为很多企业不知道怎么出海,帮助企业快速出海,一站式解决问题的项目,也比较有市场。
前沿科技:硬科技、生物医药、航空航天、低空经济
近年来,硬科技一直是国家政策大力支持的领域。中国的硬科技方面,有的领域成熟,已经发展到了国际领先,但还有一些行业在追赶国际水平,努力发展国产替代,这些领域往往需要资本、创新创业力量去发力,投资人也乐于在这些领域押注。
“创业投资一定要跟随国家大的趋势、方向,这样更有可能得到发展红利。”梅花创投创始合伙人吴世春表示。
梅花创投近年来的关注点主要在硬科技方面。吴世春把硬科技领域的投资总结为七个字,“新半军数智航生”,指的是新能源/新材料、半导体、军工、大数据、智能制造、商业航天、生物科技七大领域。
最新的中央经济工作会议提到了要打造商业航天、低空经济等战略性新兴产业。
据此吴世春认为,2024年商业航天会有一个大的爆发。国外一些公司在这一领域取得了不少突破,中国的创业者也会迎头赶上。梅花创投在这方面布局比较广,投资了星河动力、微纳星空、星移联信等。
近年来科技方面还有一大热门领域是“低空经济”。
“低空经济”是指以民用有人驾驶和无人驾驶航空器为主,以载人、载货及其他作业等多场景低空飞行活动为牵引,辐射带动相关领域融合发展的综合性经济形态。低空经济主要包括低空制造、低空飞行、低空保障和综合服务等产业。
创投圈也在积极抓住低空经济产业密集创新和高速发展的黄金窗口期,这其中的芯片、动力系统、传感器等关键技术都有不小的发展空间,这些技术可以广泛用在物流、农业、测绘、电力巡检、安全巡逻、应急救援等领域。
杜雨提到,“低空经济”是他们主要关注的领域,他最近看的一个项目做的是农业AI。如今,无人机、物联网遥感等技术已经在农业领域有了广泛的落地应用,大疆农业推出的农业无人机针对农田喷洒、播撒、林业飞防等场景作业。另一家无人机公司极飞科技近年来已经完成了来自高瓴资本等的多轮投资。
杜雨还看好生物科学、医疗等领域的投资前景,具体包括免疫疗法、合成生物、AI制药等。
他指出,人工智能对于生物学的推动,让今天的科研效率大幅提高,获得2023年诺贝尔生理学或医学奖的就是mRNA疫苗相关的免疫疗法,现在有很多公司用AI来做免疫疗法研发。
合成生物方面,他提到,近年来美国已经在这方面取得了一定成果,顺应技术扩散规律,接下来在亚太地区应该也会看到更多合成生物学的进展。深圳理工大学等已经单独设立合成生物学院,这方面的投资前景是明确的。
“AI制药是一个既有商业价值,又有民生意义的领域,”杜雨表示,AI能够加速新药研发,对于很多病人来说,药物研发是在跟时间赛跑,它的价值不言而喻。
吴巍也提到,随着人口老龄化趋势的加剧,健康科技将成为一个备受关注的领域,包括数字健康、远程医疗、个性化医疗等方向,接下来基因编辑、个性化药物、医疗大数据等领域可能会引起更多投资关注,以推动医疗保健领域的创新。
吴世春在硬科技领域有自己的投资逻辑,他认为合格的项目需要有组合完整的团队,而不只是一个科研式企业。他把团队需要的人员组合总结为:“MSOTC”,M是一家公司的管理梦想者、造梦者,S是超级销售,O是行业老炮,T是技术领军,C是内容头部负责人。
不过,在这些领域创业要承认一个客观事实,高精尖科学方面的人才在这方面有机会,普通创业者很难突破。
吴世春给普通创业者的建议是:“打不过就加入”。他表示,中小创业者要看清市场大势,宁愿放弃自己做的小赛道,也要加入大的浪潮里,而且硬科技领域还需要技术、销售、内容等人才,找到优秀的团队加入他们,可能会因为整个项目成就更大,个人收获也更大。
结语
2023年,下一个十年发展所需要的驱动技术已经亮相,2024年,舞台上的表演即将开始。
过去几年的创业投资已经表明,一味地追逐风口,以融资为目的,讲故事、画大饼、过度依赖资本的创业方式早就行不通了,泡沫过后,登高只会让创业者跌得更重。
这一阶段,投资更加冷静,创业要求更高。在新的时代机会面前,创业者既要大胆向前,积极拥抱新浪潮,也要回归真实的用户需求,找准市场机会,注重业务本身的真实价值,不盲目、不投机,练好基本功,谨慎、严肃地创业。
*题图及文中配图来源于Unsplash。
*定焦(dingjiaoone)


评论